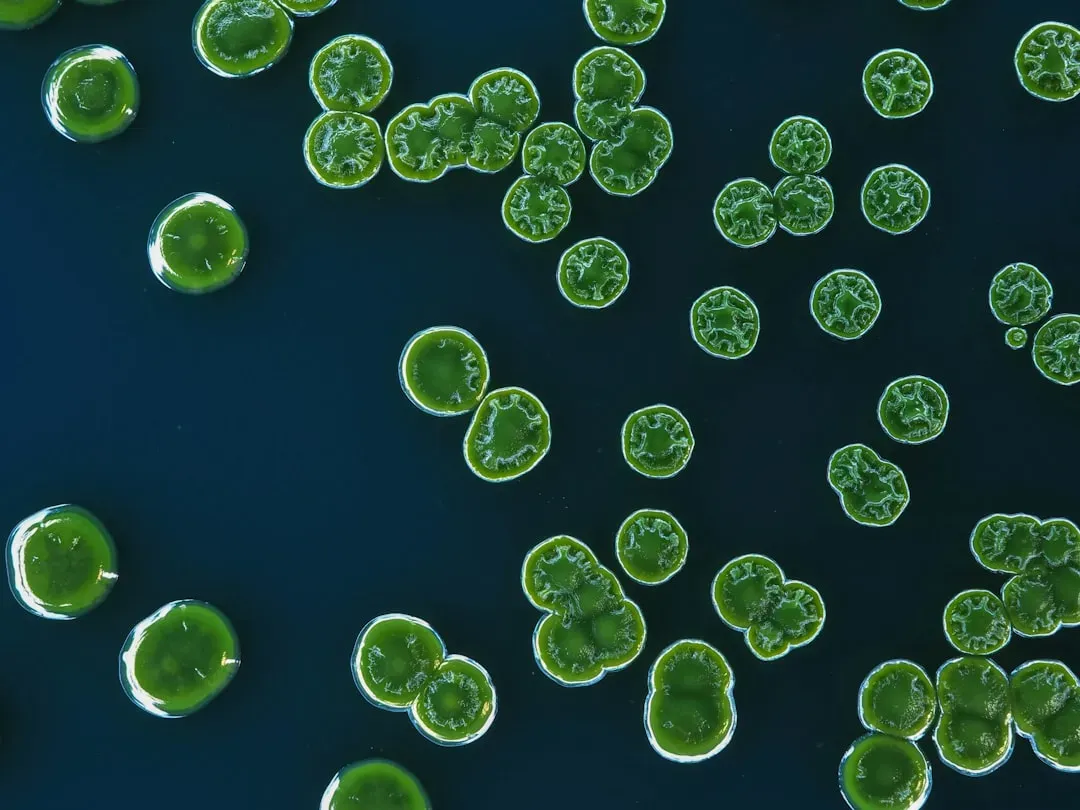
1. The Dawn of Multicellular Life: When Cells Decided to Cooperate (Image Credits: Unsplash)

Life on Earth is one of the most astonishing stories ever told. It stretches back billions of years, riddled with jaw-dropping turns, dead ends, explosive bursts of creativity, and near-total collapses that somehow gave rise to even greater complexity. Most people vaguely know that dinosaurs once ruled the planet and fish eventually grew legs. But the full story is so much stranger and more spectacular than that.
What you are about to read is not just a list of milestones. These are turning points so profound that without even one of them, every creature alive today, including you, would simply not exist. So let’s dive in.
1. The Dawn of Multicellular Life: When Cells Decided to Cooperate
Think of it this way: for most of Earth’s history, life was essentially microscopic and solo. Individual cells drifted through ancient oceans doing their own thing. Then something extraordinary happened. When looking at the fossil record and comparing different creatures alive today, we can see that during the evolutionary history of life, several dramatic jumps in complexity occurred. These jumps are so big that, at first glance, they don’t seem easily explained by simple Darwinian evolution alone. The shift from single-celled organisms to multicellular life stands as one of the most pivotal leaps of all.
Scientists think that cells of some protist colonies became specialized for different jobs. After a while, the specialized cells came to need each other for survival. Thus, the first multicellular animal evolved. It is honestly hard to overstate how radical this was. Cooperation between cells, each giving up some independence for the benefit of the whole organism, opened a door that had been locked shut for billions of years. Everything from earthworms to elephants owes its existence to that first cellular pact.
2. The Ediacaran Explosion: The First Animals Appear on Stage

Uploaded by FunkMonk, CC BY-SA 2.0)
Animals first appeared in the Ediacaran Period, about 635 million to 541 million years ago, as soft-bodied forms that left traces of their bodies in shallow-water sediments. If you could travel back and snorkel through those ancient seas, you would encounter a world almost completely alien to modern eyes. By about 580 million years ago there was a proliferation of organisms in addition to sponges. These varied seafloor creatures, with bodies shaped like fronds, ribbons, and even quilts, lived alongside sponges for 80 million years.
Most of the Ediacaran animals were thin, with each cell able to diffuse nutrients from the water, and many may have photosynthesized with symbiotic algae. These were not animals as you would recognize them today. No eyes, no legs, no complex organs. Yet they represent the very first chapter of the animal kingdom. Fossils from South Australia date back 650 million years, placing the putative animal before the great ice age extinction event that marked the transition between the Cryogenian period and the Ediacaran period. Until this discovery, most scientists believed that there was no animal life prior to the Ediacaran period. Many scientists now believe that animals may in fact have evolved during the Cryogenian period. That keeps pushing the origins of life even further back, which is nothing short of stunning.
3. The Cambrian Explosion: Evolution’s Greatest Burst of Creativity

Here is where things get truly wild. The most rapid diversification and evolution of animal species in all of history occurred during the Cambrian period of the Paleozoic Era, a phenomenon known as the Cambrian explosion. Imagine compressing nearly all of the animal body plans you will ever encounter in nature into a geological blink of an eye. We have 4 billion years of evolutionary history where not much is showing up in the rock record, and then within 20 or 30 million years, we get this burst of new body plans. In that time, animals evolved hard shells, primitive backbones, and the ancestors of nearly every creature on Earth today.
Echinoderms, mollusks, worms, arthropods, and chordates arose during this period. Some of the creatures that appeared were genuinely bizarre. A predator of the Cambrian was the giant, shrimplike Anomalocaris, which trapped its prey in fearsome mouthparts lined with hooks. Even stranger was the five-eyed Opabinia, which caught its victims using a flexible clawed arm attached to its head. Scientists still debate exactly what ignited this explosion. There is no one aspect that can be held up as the cause of this period of rapid evolution, but it is best viewed as a swirling together of factors. It was around this time that massive amounts of nutrients that had eroded from continental rocks on land were washed into the oceans, providing the calcium and phosphorus needed to build skeletons and hard shells.
4. Animals Conquer the Land: From Fins to Feet

http://nsf.gov/news/mmg/mmg_disp.cfm?med_id=58310
http://nsf.gov/news/news_summ.jsp?cntn_id=106807
https://flickr.com/photos/nsf_beta/3705198718, Public domain)
It’s hard to overstate how much of a game-changer it was when vertebrates first rose up from the waters and moved onshore about 390 million years ago. That transition led to the rise of the dinosaurs and all the land animals that exist today. Let’s be real, this is perhaps the single most dramatic physical transformation in vertebrate history. An animal built to swim essentially redesigned itself, from the inside out, to conquer an entirely new world. The transition from an aquatic, lobe-finned fish to an air-breathing amphibian was a significant and fundamental one in the evolutionary history of the vertebrates. For an organism to live in a gravity-neutral aqueous environment, then colonize one that requires an organism to support its entire weight and possess a mechanism to mitigate dehydration, required significant adaptations within the overall body plan, both in form and in function.
Many of these species were also the first to develop adaptations suited to terrestrial over aquatic life, such as neck mobility, more efficient lungs, air-transmitted hearing, water-retaining skin, and a robust skeletal structure for limb weight-bearing and terrestrial locomotion. One remarkable transitional fossil, Tiktaalik, was discovered in the Canadian Arctic. It has a fin, but the fin has bones within it similar to mammalian tetrapods. It has an upper arm bone, a lower arm bone, forearm bones, a wrist, and fingerlike projections. Essentially, it is a fin that can support the animal. Nature was literally building a hand from a paddle, one fossil at a time.
5. The Amniotic Egg: The Invention That Freed Life From Water

You might not think of an egg as revolutionary technology, but consider this: before the amniotic egg evolved, vertebrates were still chained to water for reproduction. Amphibians could venture onto land, but they always had to return to lay their eggs. The first fully terrestrial vertebrates were amniotes, animals that produce eggs with internal membranes. The membranes let gases but not water pass through. Therefore, in an amniotic egg, an embryo can breathe without drying out. Amniotic eggs were the first eggs that could be laid on land.
The earliest amniotes evolved about 350 million years ago. Within a few million years, two important amniote groups evolved: synapsids and sauropsids. Synapsids evolved into mammals. The sauropsids gave rise to reptiles, dinosaurs, and birds. Think about that branching point for a moment. One ancient lineage splitting in two, and one branch eventually becoming every reptile and bird alive today, the other becoming every mammal, including you. That humble shelled egg essentially wrote the blueprint for terrestrial vertebrate life as we know it. It is one of evolution’s most underappreciated masterstrokes.
6. The Great Permian Extinction: Catastrophe as a Catalyst

Sometimes the most dramatic evolutionary shift is not a creative leap forward, but a near-total collapse that forces life to start again. Mass extinctions of the past testify to major changes, some perhaps catastrophic, the causes of which are still debated. These mass extinctions tended to eliminate more active and specialized groups, partly setting broad-scale evolution back and selecting for the inactive and resistant. The Permian extinction, roughly 252 million years ago, was the worst of all. The catastrophic mass extinction at the end of the Permian, around 252 million years ago, killed off about 70% of terrestrial vertebrate species and the majority of land plants. As a result, ecosystems and food chains collapsed, and the establishment of new stable ecosystems took about 30 million years.
Honestly, it is almost incomprehensible. The planet was left largely barren, a near-empty stage awaiting new actors. With the disappearance of the gorgonopsians, which were dominant predators in the late Permian, the cynodonts’ principal competitors for dominance of the carnivorous niches were a previously obscure sauropsid group, the archosaurs, which includes the ancestors of crocodilians and dinosaurs. In other words, the extinction did not end the story. It reshuffled the entire cast and effectively set the stage for the age of dinosaurs. Disaster, it turns out, is one of evolution’s most powerful engines of change.
7. The Rise of Warm Blood: How Mammals and Birds Rewrote the Rules

For hundreds of millions of years, most animals were cold-blooded, dependent on external heat sources to power their bodies. Then two separate lineages, birds and mammals, independently evolved the ability to generate their own internal heat. This sounds like a minor metabolic detail, but it was nothing short of a revolution. The nocturnal lifestyle may have contributed greatly to the development of mammalian traits such as endothermy and hair. Early mammals, forced into the shadows by dinosaur predators, likely evolved warm-bloodedness as a survival tool, enabling them to stay active and hunt insects through cold nights when reptiles were sluggish and inactive.
Plants died, herbivores and carnivores starved, and the mostly cold-blooded dinosaurs ceded their dominance of the landscape to more warm-blooded mammals. In the following Cenozoic Era, mammals radiated into terrestrial and aquatic niches once occupied by dinosaurs, and birds, the warm-blooded offshoots of one line of the ruling reptiles, became aerial specialists. Warm blood meant independence from the sun’s schedule. It meant surviving in cold climates, colonizing high altitudes, and staying active year-round in ways that cold-blooded animals simply could not. The most fundamental change was the emergence of diurnal mammals active during the daytime, after they had been confined to more furtive nocturnal foraging or hunting by the dominance of the dinosaurs. The world, in every sense, became theirs.
8. The Mammalian Takeover After the K-Pg Extinction: Evolution’s Second Wind

Sixty-six million years ago, an asteroid impact triggered a mass extinction event, known as the K-Pg extinction, that killed off the planet’s dinosaurs. What followed was one of the most spectacular evolutionary opportunistic explosions in the entire animal record. When the asteroid struck the Yucatán Peninsula in Mexico 66 million years ago, the abrupt change in the climate led to a mass extinction. The subsequent dinosaur-shaped hole in the ecosystem was filled by a group of species that we know well: the mammals. Imagine every major ecological role on the planet suddenly becoming vacant overnight. That is essentially what happened.
Fossils revealed that following the K-Pg extinction, mammals evolved to fill the ecological niches no longer filled by dinosaurs. The pace was breathtaking. New research suggests that early mammals diversified much more rapidly than previously thought. Paleontologists from the University of Colorado in Boulder have discovered three new species of mammal that lived only a few hundred thousand years after the dinosaur extinction. Meanwhile, the appearance and dominance of flowering plants in the Cenozoic Era created new niches for insects, as well as for birds and mammals. The world was rebuilding itself, and this time mammals, including the primate lineage that would eventually produce humans, were writing the script. The rest, as they say, is history.
Conclusion

What ties all eight of these shifts together is a simple but humbling truth: life does not evolve in a straight line. It explodes, collapses, adapts, reinvents, and surprises at every turn. Every creature alive today is the product of billions of years of trial, catastrophe, and astonishing innovation. From the first cells that decided to cooperate to the mammals that rushed in to fill a dinosaur-sized void, each shift changed the direction of life on Earth in ways that could never have been predicted.
The story is far from over. Evolution has no final destination, no goal, no agenda. It simply responds to pressure, opportunity, and time. Looking back at these eight pivotal moments, it becomes clear that life is not fragile. It is relentlessly, almost stubbornly creative. So the next time you look at a bird, a whale, or even a simple spider, remember: you are looking at the result of one of the greatest, most dramatic ongoing stories in the universe. Which of these eight shifts surprises you the most? Drop your thoughts in the comments.




